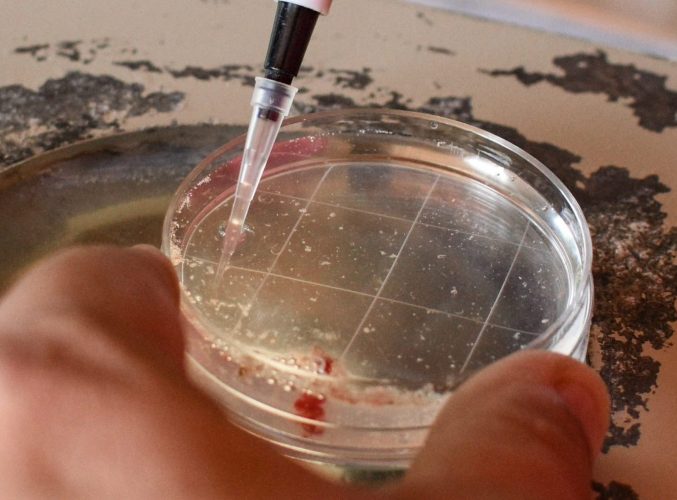

tecnologias
AVALIAÇÃO GENÉTICA
Com participação ativa nos programas de melhoramento genético da ANCP e do PMGZ a Marca 11 investe no ativo mais valioso do agronegócio, a informação de qualidade.
Através desta importante ferramenta o rebanho traça seu plano genético e identifica animais superiores a cada safra levando em conta características de impacto econômico.



AVALIAÇÃO GENÔMICA
Reforçando a crença nas avaliações, a Marca 11 investe na genômica visando aumentar a confiabilidade de suas informações. Tal ferramenta permite a identificação de animais cada vez mais jovens, reduzindo o intervalo de gerações e levando mais segurança ao cliente.


ACASALAMENTOS DIRIGIDOS
Com a consultoria especializada da “AVAL – Serviços Tecnológicos” a Marca 11 planeja a construção de cada safra.
Através de um software é possível otimizar e quantificar informações genéticas, além controlar a endogamia nos cruzamentos. Tal tecnologia permite o acasalamento individualizado das matrizes.
Por fim, grande parte do tempo de serviço fica dedicado ao curral, avaliando visualmente cada vaca com o objetivo de produzir animais morfologicamente funcionais.
PRECOCIDADE SEXUAL DE FÊMEAS
Sem sombra de dúvidas é uma das iniciativas de maior impacto dentro de uma fazenda de cria.
O processo que envolve a exposição de fêmeas à estação de monta no mesmo ano em que desmamam agrega inúmeros benefícios ao sistema de produção de uma fazenda. Dentre eles podemos citar: Eliminação de uma categoria animal; Aumento do rebanho de forma mais acelerada; A própria seleção de animais mais precoces; Um retorno financeiro em menor tempo.
Portanto, a seleção virtuosa para precocidade sexual não poderia ficar de fora do portifólio de tecnologias do Nelore Marca 11.



ULTRASSONOGRAFIA DE CARCAÇA
Na incansável busca por identificar indivíduos superiores, adotamos a tecnologia de maior impacto frigorífico dentro dos programas de seleção. A ultrassonografia nos permitiu conhecer a fundo o nosso rebanho, compreendendo a composição de peso e a qualidade de carcaça de cada animal.
Seguindo um rígido protocolo de coleta de imagens, com a atuação de profissionais certificados pela UGC (Ultrasound Guidelines Council), são coletadas as seguintes medidas:
- Área de Olho de Lombo (AOL): Medida obtida através do músculo do contrafilé, a partir do qual é possível estimar o potencial de rendimento de carcaça;
- Acabamento: Medida que avalia a espessura de gordura subcutânea. Animais com boa deposição de gordura em idade jovem apresentam um maior potencial de acabamento de carcaça, além de ter grande influência na maturidade sexual das fêmeas.
FIV (FECUNDAÇÃO IN VITRO)
Com o objetivo de multiplicar os melhores indivíduos do rebanho, buscamos a tecnologia da transferência de embriões.
Ferramenta indispensável em qualquer programa de seleção, a FIV viabilizou um rápido crescimento do rebanho auxiliando na padronização dos nossos produtos.
Para obtermos sucesso na escolha da genética a ser multiplicada, precisamos andar juntos com os acasalamentos dirigidos, como um sistema com várias engrenagens interdependentes.
Nelore Marca 11 © 2024 – Todos os direitos reservados
Desenvolvido pela Hostmain Soluções Web ∴

